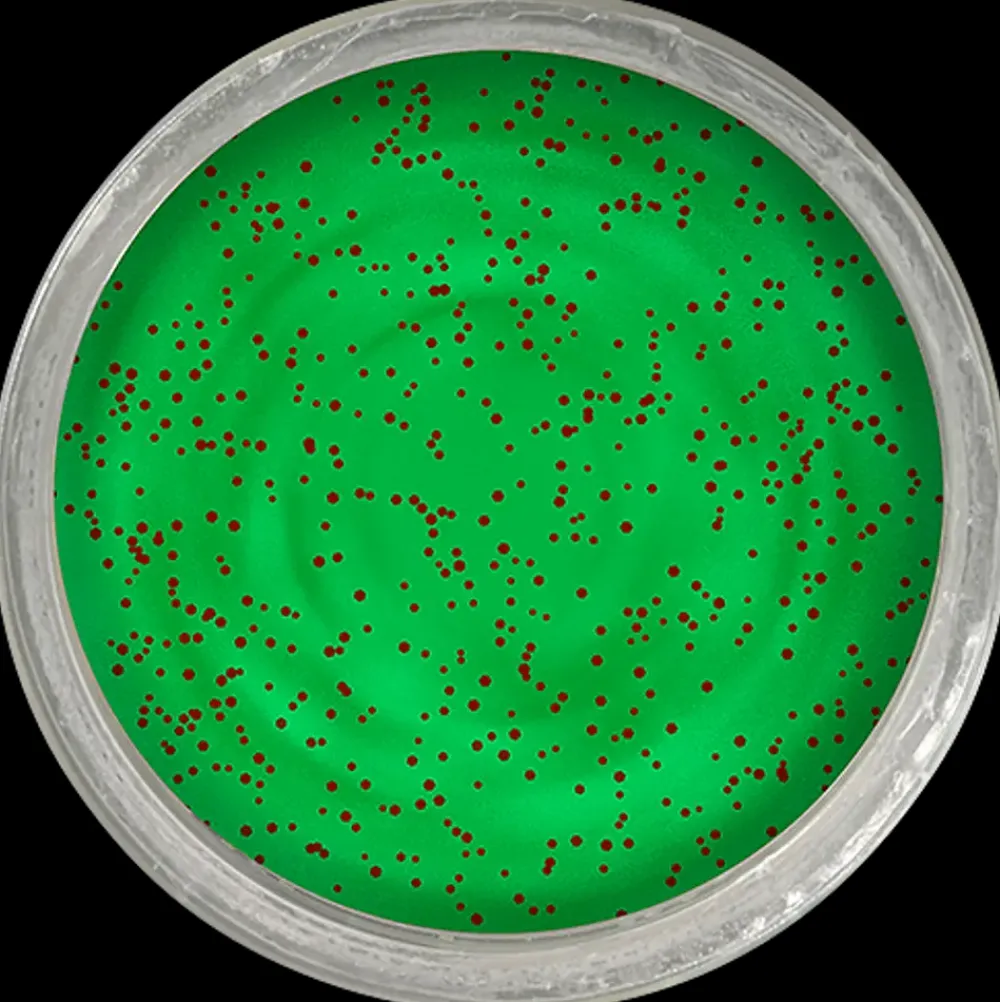

- Ideel til regnbueørreder
- Effektiv til Put & Take-søer
- Tilsat glitter for synlighed
- Kultfavorit blandt lystfiskere
- Duft og smag lokker ørreder
Berkley PowerBait Apple Jack| Endegrej Og Madding
kr.34.50 Original price was: kr.34.50.kr.27.53Current price is: kr.27.53.
Varenummer (SKU): SKUvCYpwwxhox Kategorier: Endegrej Og Madding, Jagt, Fiskeri, Marine Og Outdoor, Sport Og Fritid Tag: Berkley PowerBait Varemærke: Berkley PowerBait
PowerBait er uden sammenligning en af de mest effektive kunstagn til fiskeri i Put & Take-søer og har opnået nærmest kultstatus blandt lystfiskere verden over.Den unikke PowerBait-formel kombinerer en lokkende duft og smag, som er specielt udviklet til at tiltrække ørreder og har gang på gang bevist sine fremragende fangstegenskaber. Denne variant er tilsat glitter, som ikke kun øger synligheden, men også gør det lettere at lokke fisk i uklart og grumset vand. PowerBait er nem at forme og tilpasse, hvilket gør det muligt at anvende den med forskellige fisketeknikker. Desuden sidder den sikkert fast på krogen, hvilket giver større tryghed under fiskeri. PowerBait fås i mange farver og dufte, så du kan finde den rette variant til enhver fiskesituation. Denne version er særligt velegnet til fiskeri efter regnbueørreder og kan bruges af både nybegyndere og erfarne lystfiskere.
Vær den første til at anmelde “Berkley PowerBait Apple Jack| Endegrej Og Madding” Annuller svar
Relaterede varer
Tilbud!
Løbebånd
Jagt, Fiskeri, Marine Og Outdoor
kr.213.83
Tilbud!
Skadebehandling Og Massage
Tilbud!
Motionsmaskiner
Tilbud!
Bordtennis Og Tilbehør
Jagt, Fiskeri, Marine Og Outdoor
kr.20.63
Tilbud!
Tilbud!
Auto- Og Trailertilbehør
Stanford Universalreb 8 mm 20 m| Reb Og Tov|Presenninger Og Fortøjning
Tilbud!
Endegrej Og Madding
Berkley PowerBait PowerBait Peach & Pep Glitter| Endegrej Og Madding
Øvrige Reservedele
kr.40.64

Anmeldelser
Der er endnu ikke nogle anmeldelser.